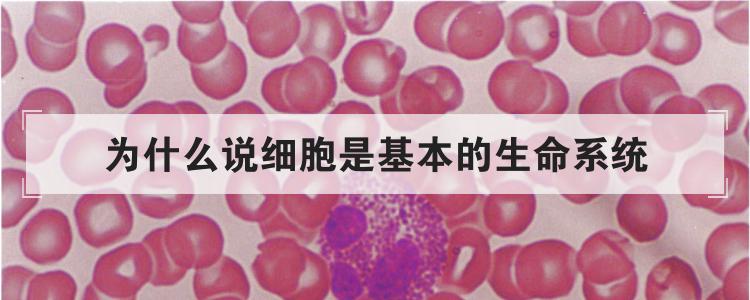
为什么说细胞是基本的生命系统

最佳回答
本文由作者推荐
简要回答
大家都知道世界上最大的生态系统是生物圈,地球上最基本的生命系统是细胞。那这是为什么呢?下面就来说说为什么说细胞是最基本的生命系统。
详细内容
详细内容
- 01
因为所有的生命都是以细胞为基础构建的。对于单细胞生物来说,细胞就是它的生物体本身,对于多细胞生物来说,细胞是执行其生命活动的基本单位,而对于一些没有细胞结构的生物来说,它们只有通过寄生于细胞内才能繁殖后代并以此表现出生命特征。因此说,细胞是最基本的生命系统。

- 02
细胞并没有统一的定义,比较普遍的提法是:细胞是生物体基本的结构和功能单位。已知除病毒之外的所有生物均由细胞所组成,但病毒生命活动也必须在细胞中才能体现。

- 03
一般来说,细菌等绝大部分微生物以及原生动物由一个细胞组成,即单细胞生物,高等植物与高等动物则是多细胞生物。细胞可分为原核细胞、真核细胞两类,但也有人提出应分为三类,即把原属于原核细胞的古核细胞独立出来作为与之并列的一类。研究细胞的学科称为细胞生物学。

- 04
细胞体形极微,在显微镜下始能窥见,形状多种多样。主要由细胞核与细胞质构成,表面有细胞膜。高等植物细胞膜外有细胞壁,细胞质中常有质体,体内有叶绿体和液泡,还有线粒体。动物细胞无细胞壁,细胞质中常有中心体,而高等植物细胞中则无。细胞有运动、营养和繁殖等机能。

广告位
点击排行
- 2 排行
- 3 排行
- 4 排行
- 5 排行
- 6 排行
- 7 排行
- 8 排行
- 9 排行
- 10 排行
广告位





















